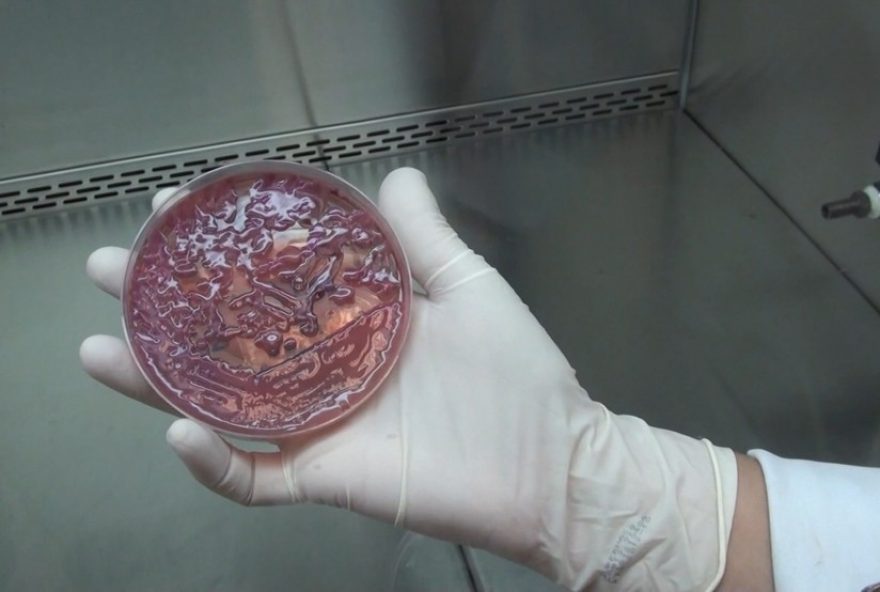
familia-denuncia-risco-de-contagio-por-kpc-no-hospital-mario-gatti familia-denuncia-risco-de-contagio-por-kpc-no-hospital-mario-gatti

Família de paciente internada no Hospital Mário Gatti cita risco de contágio por KPC
O Hospital Mário Gatti, em Campinas (SP), identificou mais um caso de contaminação com a bactéria Klebsiella Pneumoniae Carbapenemase, conhecida pela sigla KPC. Desta vez, na enfermaria da unidade, e não na UTI, que tem nove casos confirmados e foi fechada por conta do surto.
Um vídeo feito por familiares de uma paciente, nesta quinta-feira (19), mostra que entre os leitos na enfermaria, há um com uma placa alertando sobre o risco de contaminação: “Precaução de contato, KPC”, diz o texto – assista acima.
Rede Mário Gatti rebate afirmações da família
Em nota, a Rede Mário Gatti, responsável pelo hospital municipal, defendeu que se trata de um caso isolado na enfermaria, que não tem qualquer relação com o surto registrado na UTI adulto.
Segundo a rede, “a identificação de pacientes com micro-organismos multiresistentes, como a KPC, faz parte das rotinas de vigilância e segurança assistencial do hospital”.
Ainda de acordo com a Rede Mário Gatti, após o resultado pronto na tarde desta quinta, as equipes iniciaram medidas de precaução de contato e um quarto privativo foi liberado para isolamento da paciente, que deve ser transferida nas próximas horas.
O que é a KPC e como surge?
A KPC faz parte de um grupo de bactérias que são resistentes a antibióticos, por isso, é chamada de superbactéria. O agente infeccioso produz uma enzima que destrói vários antibióticos, medicamentos mais usados em casos de infecções bacterianas. A superbactéria foi identificada no Brasil no início dos anos 2000; desde então, surtos são registrados de tempos em tempos em unidades de saúde.
Segundo o infectologista e professor da Unicamp, Plínio Trabasso, o surgimento desse tipo de bactéria é uma consequência da utilização de antibióticos potentes no ambiente hospitalar ao longo dos anos.
Sintomas, prevenção e impactos da KPC
Ainda de acordo com Trabasso, as infecções mais comuns em diagnósticos de KPC são infecções de corrente sanguínea (sepse), pneumonia, infecções do trato respiratório, infecções urinárias, embora menos frequentes, e infecções de feridas operatórias.
O médico infectologista ressalta a necessidade de ter atenção e cuidado, em especial, para a população em geral realizar sempre higiene das mãos, seja com água e sabão comum ou com álcool gel, após ter contato com as pessoas, e para os profissionais de saúde obedecer as regras específicas de higiene e segurança.